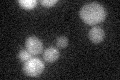
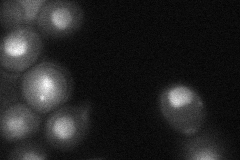

View description
Highly conserved nuclear protein required for actin cytoskeleton organization and passage through Start, plays a critical role in G1 events, binds Nap1p, also involved in 60S ribosome biogenesis
Localization:
Intensity:
Fold change:
Significance:
-
C’ GFP library in SD
below threshold17.53 -
N' NOP1pr-GFP in SD

nucleus,nucleolus128.153 -
N' TEF2pr-mCherry in SD

nucleus,nucleolus100.368 -
N' NATIVEpr-GFP in SD

cytosol42.2525 -
N' TEF2pr-VC and Cyto-VN in SD
nucleus,nucleolus43.959 -
C’ GFP library in SD+DTT

cytosol16.470.93No -
C’ GFP library in SD+H2O2

cytosol17.961.02No -
C’ GFP library in Starvation Media

cytosol18.551.05No -
C’ GFP library on the background of Pup2-DaMP

below threshold -
C’ GFP library on the background of CCT mutant

below threshold16.84450.960388No
